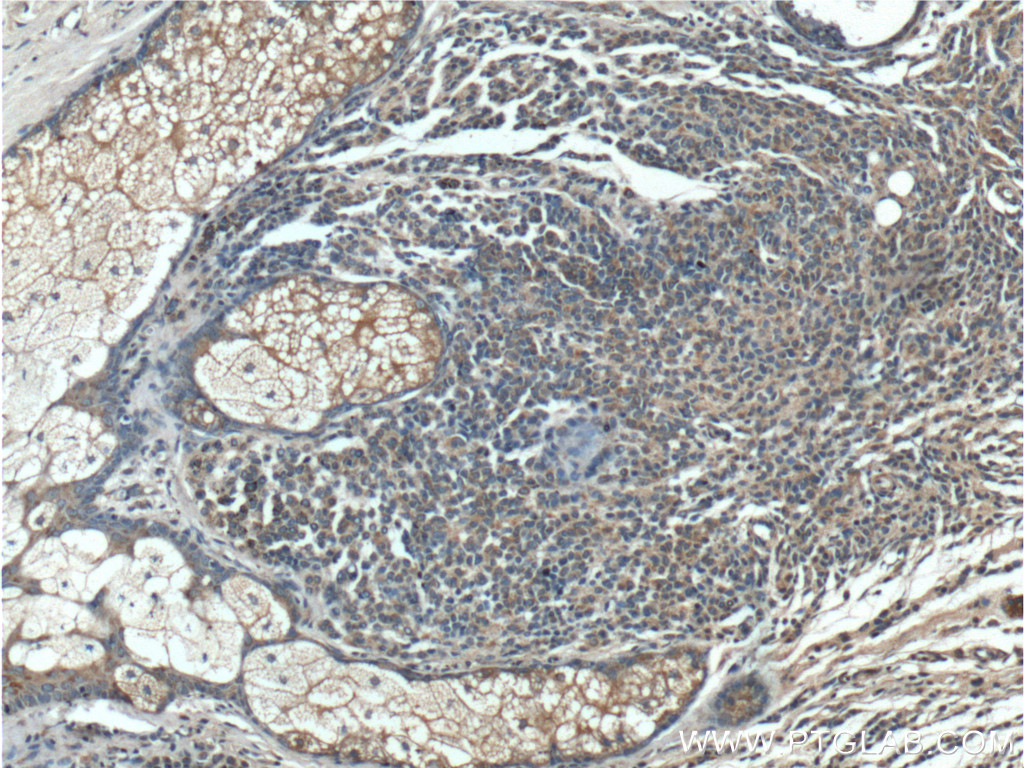

验证数据展示
经过测试的应用
| Positive WB detected in | HT-29 cells, HEK-293 cells, HeLa cells, K-562 cells, Jurkat cells, NIH/3T3 cells |
| Positive IHC detected in | human lymphoma tissue, human malignant melanoma tissue, human testis tissue, human thyroid cancer tissue Note: suggested antigen retrieval with TE buffer pH 9.0; (*) Alternatively, antigen retrieval may be performed with citrate buffer pH 6.0 |
| Positive IF/ICC detected in | NIH/3T3 cells, HeLa cells |
推荐稀释比
| 应用 | 推荐稀释比 |
|---|---|
| Western Blot (WB) | WB : 1:1000-1:4000 |
| Immunohistochemistry (IHC) | IHC : 1:250-1:1000 |
| Immunofluorescence (IF)/ICC | IF/ICC : 1:200-1:800 |
| It is recommended that this reagent should be titrated in each testing system to obtain optimal results. | |
| Sample-dependent, Check data in validation data gallery. | |
产品信息
20899-1-AP targets BRAF in WB, IHC, IF/ICC, ELISA applications and shows reactivity with human, mouse samples.
| 经测试应用 | WB, IHC, IF/ICC, ELISA Application Description |
| 文献引用应用 | WB, IHC, IF |
| 经测试反应性 | human, mouse |
| 文献引用反应性 | human, mouse, chicken |
| 免疫原 |
CatNo: Ag15014 Product name: Recombinant human BRAF protein Source: e coli.-derived, PGEX-4T Tag: GST Domain: 500-766 aa of BC101757 Sequence: NEVGVLRKTRHVNILLFMGYSTKPQLAIVTQWCEGSSLYHHLHIIETKFEMIKLIDIARQTAQGMDYLHAKSIIHRDLKSNNIFLHEDLTVKIGDFGLATVKSRWSGSHQFEQLSGSILWMAPEVIRMQDKNPYSFQSDVYAFGIVLYELMTGQLPYSNINNRDQIIFMVGRGYLSPDLSKVRSNCPKAMKRLMAECLKKKRDERPLFPQILASIELLARSLPKIHRSASEPSLNRAGFQTEDFSLYACASPKTPIQAGGYGAFPVH 种属同源性预测 |
| 宿主/亚型 | Rabbit / IgG |
| 抗体类别 | Polyclonal |
| 产品类型 | Antibody |
| 全称 | v-raf murine sarcoma viral oncogene homolog B1 |
| 别名 | B RAF1, BRAF1, EC:2.7.11.1, p94, Proto-oncogene B-Raf |
| 计算分子量 | 766 aa, 84 kDa |
| 观测分子量 | 65-70 kDa |
| GenBank蛋白编号 | BC101757 |
| 基因名称 | BRAF |
| Gene ID (NCBI) | 673 |
| RRID | AB_2878760 |
| 偶联类型 | Unconjugated |
| 形式 | Liquid |
| 纯化方式 | Antigen affinity purification |
| UNIPROT ID | P15056 |
| 储存缓冲液 | PBS with 0.02% sodium azide and 50% glycerol, pH 7.3. |
| 储存条件 | Store at -20°C. Stable for one year after shipment. Aliquoting is unnecessary for -20oC storage. |
背景介绍
B-Raf proto-oncogene serine/threonine kinase(BRAF), is a protein belonging to the raf/mil family of serine/threonine protein kinases. BRAF plays a role in regulating the MAP kinase/ERKs signaling pathway, which affects cell division, differentiation, and secretion. BRAF is associated with cardiofaciocutaneous syndrome, a disease characterized by heart defects, mental retardation and a distinctive facial appearance. BRAF is also associated with various cancers, including non-Hodgkin lymphoma, colorectal cancer, malignant melanoma, thyroid carcinoma, non-small cell lung carcinoma, and adenocarcinoma of lung. BRAF plays a role in the PD-1/PDL-1 pathway. In some cancers, BRAF is activated by rearrangements that fuse its kinase domain to 5' partner genes and then has different molecular weights (PMID: 23890088). BRAF has several isoforms, the calculated molecular weight of BRAF is 84 kDa, but the observed molecular weight is about 65 kDa(isoform).
实验方案
| Product Specific Protocols | |
|---|---|
| IF protocol for BRAF antibody 20899-1-AP | Download protocol |
| IHC protocol for BRAF antibody 20899-1-AP | Download protocol |
| WB protocol for BRAF antibody 20899-1-AP | Download protocol |
| Standard Protocols | |
|---|---|
| Click here to view our Standard Protocols |
发表文章
| Species | Application | Title |
|---|---|---|
Acta Pharmacol Sin 1-Indanone retards cyst development in ADPKD mouse model by stabilizing tubulin and down-regulating anterograde transport of cilia | ||
J Eur Acad Dermatol Venereol Differentially expressed proteins identified by TMT proteomics analysis in children with verrucous epidermal naevi. | ||
Biochim Biophys Acta Mol Cell Res IL-17 promotes melanoma through TRAF2 as a scaffold protein recruiting PIAS2 and ELAVL1 to induce EPHA5 | ||
Front Immunol Immune Dysfunction Mediated by the ceRNA Regulatory Network in Human Placenta Tissue of Intrahepatic Cholestasis Pregnancy. | ||
Life Sci Network pharmacology and molecular docking reveal the mechanism of Scopoletin against non-small cell lung cancer. | ||
Gene WT1 suppresses follicle-stimulating hormone-induced progesterone secretion by regulating ERK1/2 pathway in chicken preovulatory granulosa cells. |